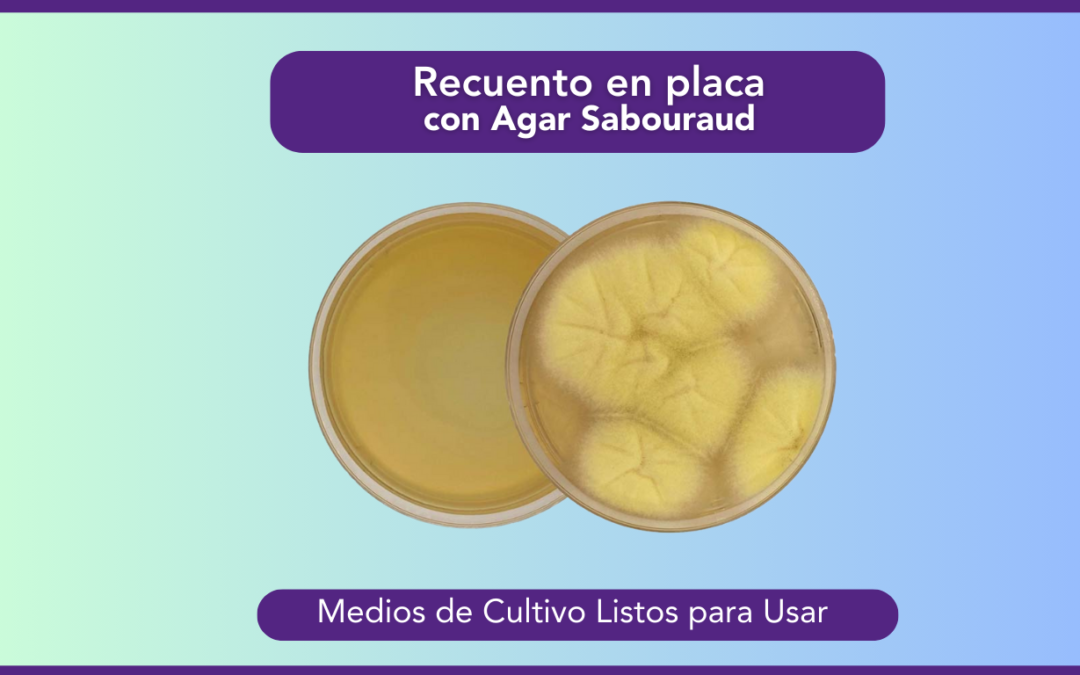
El recuento en placa con Agar Sabouraud: Lo que hay que saber
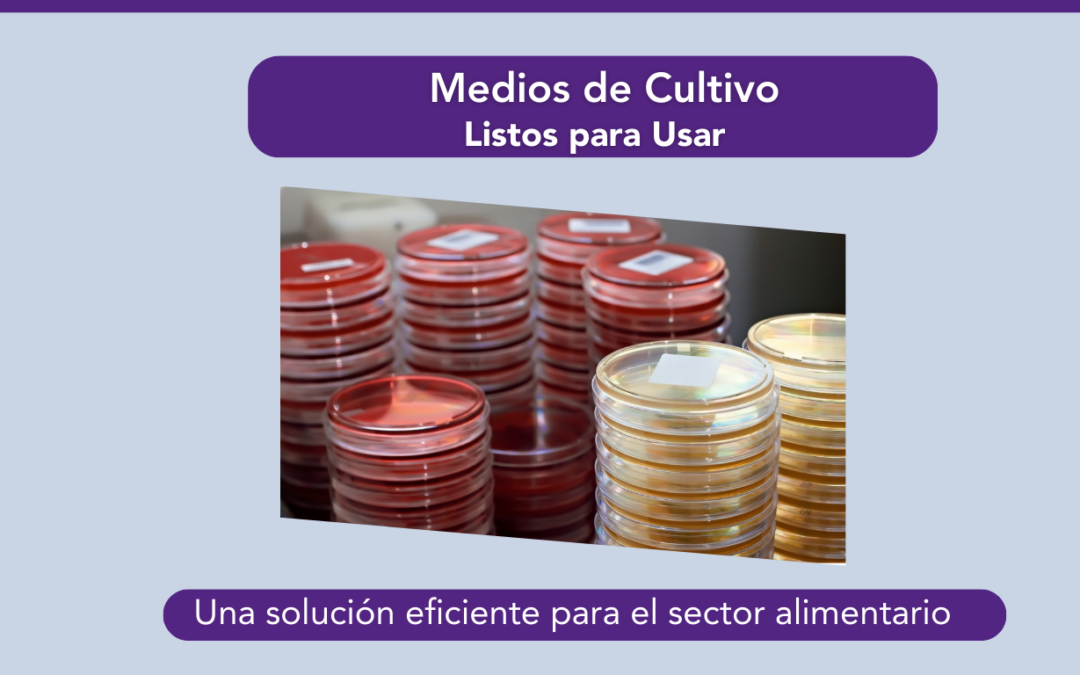
Precisión en la industria alimentaria.

by Comunicacion Marketing | Ene 20, 2025 | Blog
El recuento en placa con Agar Sabouraud es una técnica microbiológica ampliamente utilizada para el análisis y conteo de hongos y levaduras viables en diferentes tipos de muestras. Esta técnica se distingue por emplear un medio de cultivo especializado, el Agar...

by Comunicacion Marketing | Ene 16, 2025 | Blog
La diferencia entre indicadores químicos e integradores químicos es sutil y, en algunos casos, los términos se utilizan de manera intercambiable, pero la realidad es que cada uno cumple una función única y esencial para garantizar la efectividad de la esterilización....

by Comunicacion Marketing | Ene 14, 2025 | Blog
El muestreo de ambientes y matrices alimentarias en la industria de cereales y granos es un paso esencial para garantizar la calidad, seguridad y cumplimiento normativo en los procesos de almacenamiento, procesamiento y distribución. ¿Cómo se realiza y qué factores...

by Comunicacion Marketing | Ene 10, 2025 | Blog
Medios de Cultivo Listos para Usar Mikrobiol: una solución eficiente para el sector alimentario En la industria alimentaria, garantizar la inocuidad de los productos es una prioridad absoluta. Desde el monitoreo ambiental en plantas de procesamiento hasta la detección...

by Comunicacion Marketing | Ene 8, 2025 | Blog
La esterilización es un proceso crítico en diversos sectores, desde laboratorios clínicos hasta la industria alimentaria. En Mikrobiol, bajo licencia Terragene®, ofrecemos tecnología de vanguardia diseñada para garantizar altos estándares de seguridad y eficiencia. La...

by Comunicacion Marketing | Ene 6, 2025 | Blog
En los entornos que requieren la máxima seguridad, como laboratorios, hospitales e industrias, el control de la esterilización es una tarea crucial. Un proceso efectivo no solo garantiza la eliminación de microorganismos, sino que también asegura la calidad de los...